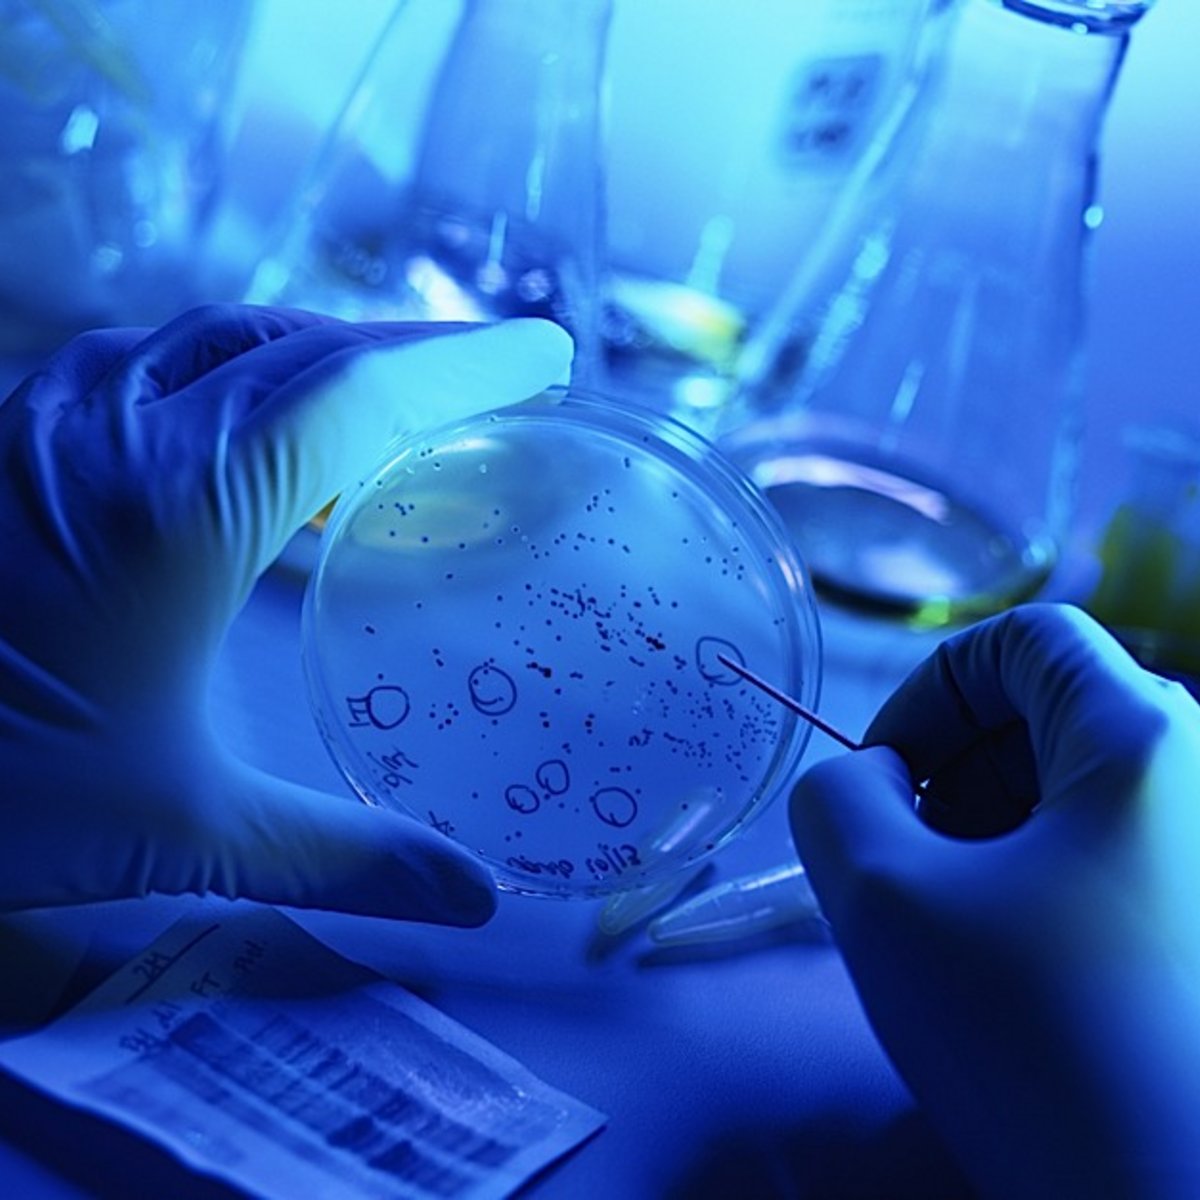
Promo image for life science industry

DRIVEN develops new life science & tech property in Berlin
The real estate developer DRIVEN Investment GmbH is planning a new life science & tech property in Berlin. Around 6,750 square meters of rental space are to be built in Moabit, not far from the Technical University, by the fourth quarter of 2026. Around 70 percent of this will be laboratory space. A preliminary building permit has already been issued. Construction is scheduled to start in spring 2025 at the latest. The financing bank for the entire project is BayernLB.
"With this project, we have the opportunity to develop an exciting life science & tech property in a unique environment," says Toğrul Gönden, managing director and life science expert at DRIVEN. "We are observing a great demand for modern laboratory space, especially in Berlin."
"With BayernLB, we know we have a reliable banking partner at our side who, despite the challenging market environment, is conceptually convinced of our project and will underwrite the financing," adds Horst Weis, Managing Director and financing expert at DRIVEN.
Bernd Mayer, Head of Real Estate, says: "With the financing of this exciting project, we are pursuing our strategy of supporting professional clients in the realization of ESG-compliant properties, despite the difficult market environment."
Michael Brumbauer, Head of Sales Berlin, adds, "I am very pleased to be able to gain a professional market participant in Driven Investment through our sales office in Berlin."
The spaces being developed are already available for pre-letting and offer a great deal of flexibility - for example, rental spaces from 300 square meters can be flexibly combined. Chemical, biological and physical laboratories in safety levels S1 - S3 are possible. Clean rooms, i.e. areas without airborne particles, are also possible depending on user requirements.
For the new building, DRIVEN relies on high ESG criteria. The aim is to achieve the DGNB sustainability standard in gold or better. Among other things, the building is to have a PV system, biodiversity roofs and a particularly high biotope area factor.
The site is located not far from Campus Charlottenburg, one of Berlin's eleven Future Places and also one of the largest inner-city university complexes in Europe. Covering 90 hectares, the Charlottenburg Campus has approximately 37,700 students, 12,200 employees and 80 companies.
For further information about the growth industries, economic development, business and technology support for companies, investors and scientific institutions in the Airport Region Berlin Brandenburg please contact:
Sandra Koletzki | sandra.koletzki(at)airport-region.de
(Source: DRIVEN Investment GmbH, 10|09|2023 | "DRIVEN develops new life science & tech property in Berlin")